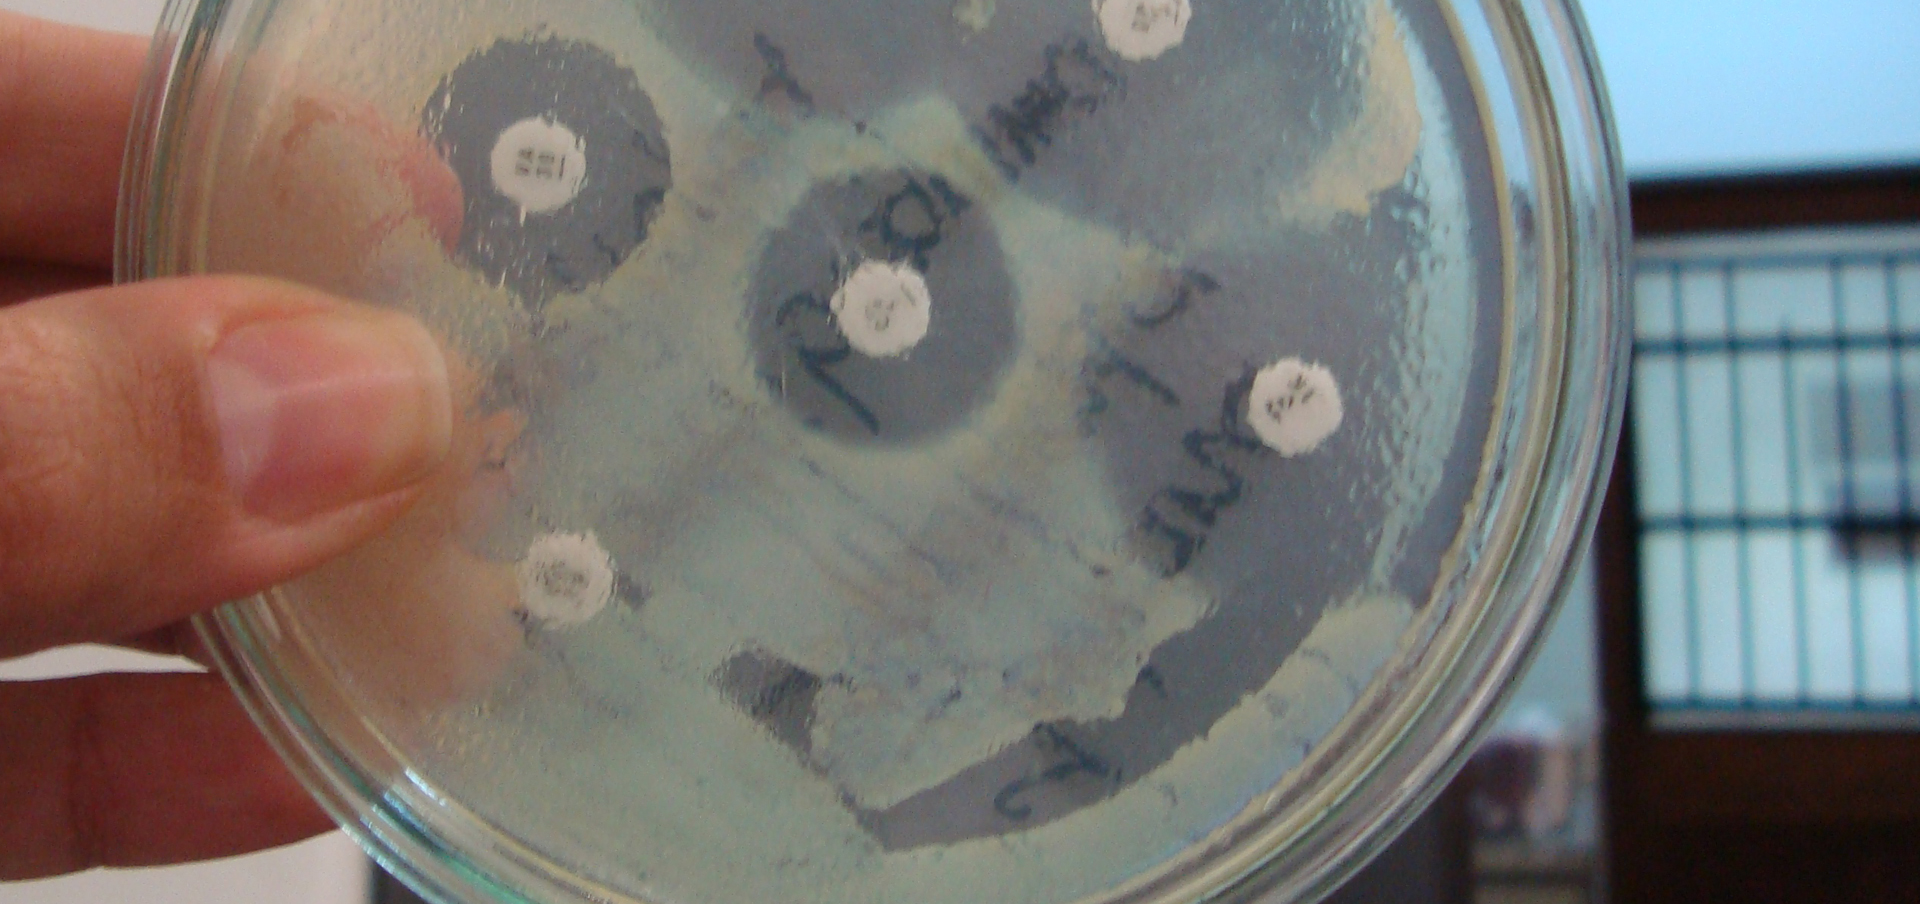
why is public health important

Around the world, public health professionals work to ensure the safety and health of the greater good. They are giving communities clean water to drink, promoting the benefits of nutrition, fighting against air pollution, facilitating access to healthcare services, developing vaccination protocols, and preventing future epidemics. But this is just a small glimpse at the valuable work that public health professionals do.
People who choose to study public health, and launch a career in the field, are often people who are passionate about helping others. They may feel a calling towards community service, but also have a love for science, research, and data. They may have been inspired by the COVID-19 pandemic, or the growing need for health equity within our communities. Everyone has their own, unique “why,” but public health workers have the same common goals of making an impact and helping those in need.
Why Should You Study Public Health?
As described above, there are many reasons why one will choose to study public health.
You may choose to pursue this field because you want to make an impact in areas like disease prevention, emergency response, or health and wellness. You may wish to put your compassion and empathy to use in your career. Alternatively, you may feel inspired to meet growing workforce demands, as more and more people are seeking solutions to health-related questions and requirements.
Now, more than ever, our population is in need of public health researchers, epidemiology experts, policy makers, campaign leaders, health advocates, and health educators. So much, in fact, that the Bureau of Labor Statistics expects faster than average job growth for public health professions. The job opportunities are boundless, and the career satisfaction is high, within the field of public health. But these are just some of the many reasons why you might pursue this area of study.
You may also wish to help populations gain access to valuable healthcare services. You may want to respond to health crises in times of need, whether natural disasters or global pandemics. You may wish to find the causes – and the solutions – for epidemics just like COVID-19. These are just some of the many reasons why you may study public health.
But if you still aren’t sure, here is a comprehensive list of reasons to study public health today.
Top Reasons to Study Public Health
1. Be at the forefront of research and change.
From immunizations to prenatal care, many of the world’s biggest breakthroughs in healthcare have stemmed from public health research. This is because, within the field of public health, professionals are consistently uncovering population trends, problematic events, environmental risks, as well as innovative and responsive treatments inside and outside the lab. That is the beauty of this field – you will consistently be at the cutting edge of healthcare. You will know the latest data, technologies, and resources. For this reason, your work will be highly respected and valued across the industry.
Goodwin University offers public health degrees at the bachelor’s and master’s degree levels. Wondering which is the right path for you? Check out our downloadable MPH and BS Public Health Get Started Guides to learn more!
2. Work with a variety of different people and populations.
If you enjoy working with people, a career in public health is a great path. As a public health expert, you will work with a variety of populations such as the elderly, the homeless, veterans, those living in poverty, and people struggling with mental health conditions. You may also work with malnourished populations, children in the welfare system, or couples trying to plan for families. These are just some of the many examples of demographics you can impact. In your unique position, you will not only experience how certain populations live, but also how to help them lead healthy, successful lives.
3. Make a difference in the lives of others.
Public health is a field primarily focused on helping the greater good and for many public health workers, this brings great pride to all that they do. In this field, you will consistently try to create healthy environments within communities, workplaces, facilities, and homes. Your role will be to improve the wellbeing of others, to help them regain the skills they need to live happily and efficiently. You will have a great impact on them and they will have a significant impact on you.
4. Opportunity to travel.
Many public health professionals choose to pursue their career without boundaries – some travel to third-world countries in efforts to improve global health. If you enjoy travelling and are looking for experience across state or national borders, public health can offer you these opportunities. You have the option to work with citizens of different countries around the world.
5. Variety of career options.
There is no doubt that public health is a seemingly “all-encompassing” field, but that is part of the beauty of it. If you are wondering what you can do with a public health degree, know that the career options are vast. From becoming a health educator to a research analyst, a public health advocate to a community health worker, there are numerous roles you can take on. At Goodwin University, you can diversify your class schedule or focus on certain areas of study in public health.
6. Great job security and growth.
Like much of the healthcare industry, job growth in this field is well above the average for all. According to the Bureau of Labor Statistics, the demand for community health workers will increase 14 percent over the next decade, while epidemiologist careers are expected to grow a massive 27 percent by 2032. Health scientists, educators, and more all expect to see an incredible spike in job openings in the coming years. Even more, job security in public health positions is extremely stable. There will always be a need for public health services. With current generations focusing on preventive care, and an aging baby boomer population requiring more health services, the need for public health professionals seems bigger than ever before.
7. Focus on social justice.
Social justice is an important topic in modern day professions, and public health professionals have the unique ability to impact social justice firsthand. Public health workers work to serve their communities and connect populations to the health care services and supports they both need and deserve.
Public health degree programs are actively preparing students for these roles, giving them knowledge around historical health structures, campaigns, and impacts, as well as strategical ways to impact the future of health care and health policy in our nation.
8. An exciting day-to-day job.
While some public health professionals work in offices behind-the-scenes, you will not come across your typical corporate job in public health. Many public health careers are hands-on, where you can actively enter communities, develop health campaigns, and make a difference directly within the environment. Those who work in research and policy-making also have an exciting opportunity to apply their personal experiences and passions to the work that they do.
9. A blend of science and art.
Public health is both a quantitative and qualitive field, and those who have a passion for data and design will thrive in this line of work. Public health workers can be found creating impactful programs to combat issues like smoking, pollution, obesity, and more—designing educational materials and campaigns to inform the public about these topics. On the other hand, public health workers will use data, evidence, and science to understand the topics on which they are focusing, and to make decisions about prevention strategies, educational tactics, and newly developed policies.
Why is Public Health Important?
Public health is an ever-important profession. The main goal of public health is to keep populations healthy and safe. Whether our communities are affected by natural disaster or a looming epidemic, public health professionals are working hard to ensure the wellbeing of everyone. They are researching disease, studying trends, developing prevention strategies, intervening in crises, facilitating health care equity, and teaching others how to live healthy lives.
Public health positively impacts our nation and our world. Due to the work of these professionals, we can better manage disease and illness, understand disabilities, create change in needing populations, and foster awareness of what “healthy” looks like today.
Millions of people across the globe are alive today because of public health initiatives – vaccinations, family planning, road safety laws, tobacco restrictions, food safety, even clean air and water standards. In fact, in the United States specifically, these very public health programs have increased the life expectancy by almost 30 years. As you can gather, public health is very important.
And this is why many people pursue this path.
If you are still asking, “Why study public health?”, remember this: There are new developments in health research, disease prevention, treatments and technologies every day. And expert, trained professionals are needed to help navigate the evolving nature of the field, and continue this important work.
To become a public health professional today, one needs to hold at least a bachelor’s degree in the field. For many impactful public health careers, a Master’s in Public Health (MPH) is required. Depending on the program you choose, you will learn the theories and methods of health behavior, as well as the skills necessary to practice in a professional environment. And through a carefully curated curriculum, you will learn the ins and outs of biology, epidemiology, disease prevention, social work, community and environmental health.
Are you ready to help create a better, safer, and healthier world? Contact Goodwin today at 800-889-3282 or check us out online to request more information.
Goodwin University is a nonprofit institution of higher education and is accredited by the New England Commission of Higher Education (NECHE), formerly known as the New England Association of Schools and Colleges (NEASC). Goodwin University was founded in 1999, with the goal of serving a diverse student population with career-focused degree programs that lead to strong employment outcomes.